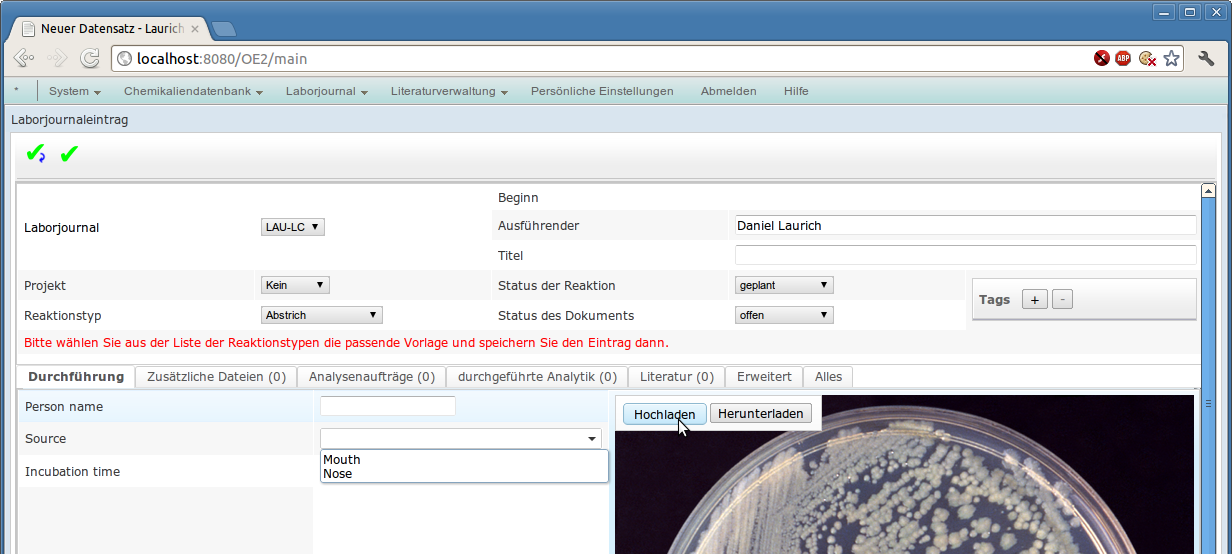

Sciformation Consulting entwickelt Software für den Einsatz in der Forschung, insbesondere für die Chemie und angrenzende Gebiete. Diese wird bei namhaften Kunden in aller Welt erfolgreich eingesetzt.
|
|||||||||||
|
Durch unsere web-basierten Programme erhalten Wissenschaftler das richtige Werkzeug, um produktiver zu forschen und langfristigen Nutzen aus den Forschungsergebnissen zu ziehen. Wofür Sie sich auch entscheiden – mit der richtigen Software werden viele Routineaufgaben im Labor einfacher und schneller erledigt, so dass sich die Forscher auf die wirklichen wichtigen Fragen konzentrieren können. Neben den Programmen bieten wir für unsere Produkte Schulungen und Support an. Sprechen Sie uns an, wir beraten Sie gerne. |
Sciformation Consulting develops software for scientific research, especially for chemistry and related fields. It is employed successfully at renowned clients worldwide.
|
|||||||||||
|
Our web-based programs allow researchers to be more productive, and to draw long-term advantage from the results. Choose the software which fits best – many routine tasks in the lab will be done quicker and easier with the right software, so that researchers can concentrate on the questions that really matter. In addition to the software itself, we offer training and support for our products. Contact us to learn more about our solutions. |